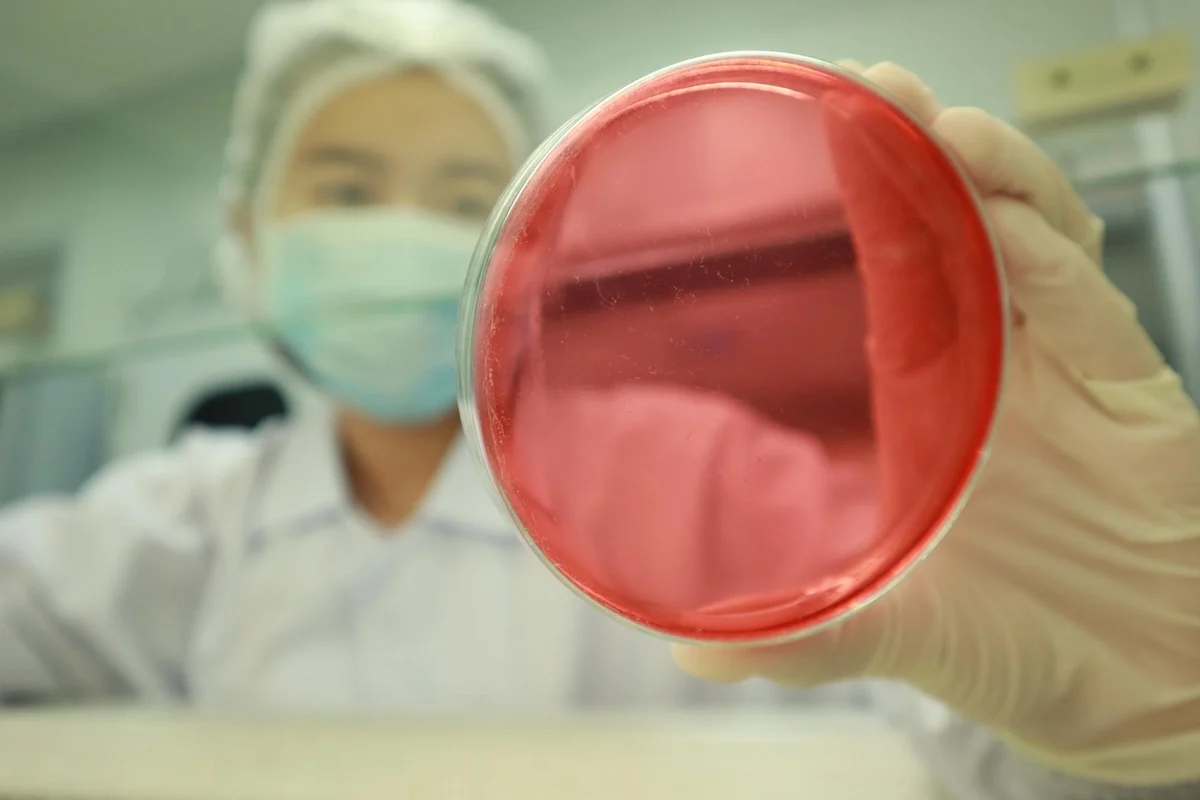

Bagaimana Cara Menggunakan Toilet Duduk yang Benar?
Banyak orang merasa bingung bagaimana cara menggunakan toilet duduk saat pertama kali menggunakannya, terutama jika sebelumnya lebih familiar dengan toilet jongkok. Selain perbedaan posisi, memahami fitur dan etika penggunaannya toilet…